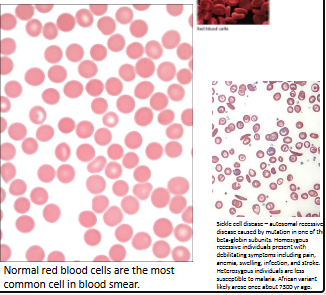
<ul><li><p>Biconcave disc-shaped cells</p></li><li><p>7–8 μm wide, 2.5 μm thick</p></li><li><p>Develop from cells in bone marrow</p><ul><li><p><strong>Lose organelles </strong>along the way</p></li><li><p>Mainly contain oxygen-carrying <strong>hemoglobin</strong></p></li><li><p>Active enzymes</p></li><li><p>E.g.<strong> carbonic anhydrase</strong>, glycolytic pathway</p></li></ul></li></ul><p></p>
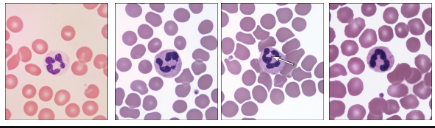
<ul><li><p>Granulocytes—<strong>neutrophils</strong></p><ul><li><p>Most abundant leukocytes (60–70% of total)</p></li><li><p>Slightly larger than RBCs</p></li><li><p>Multilobed nucleus</p></li><li><p>Small unstained or slightly lavender granules upon staining with Wright’s or Giemsa stains</p></li><li><p>Functionally short-lived phagocytic cells</p></li></ul></li></ul><p></p>
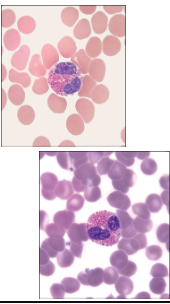
<ul><li><p>Granulocytes—<strong>eosinophils</strong></p><ul><li><p>Constitute fewer than 5% of total leukocytes</p></li><li><p>Larger than neutrophils</p></li><li><p>Bilobed nucleus</p></li><li><p>Cytoplasmic granules more pronounced and often stain reddish</p></li><li><p>Active in combating parasite infections, phagocytosing antigen- antibody complexes, and tempering allergic reactions</p></li></ul></li></ul><p></p>
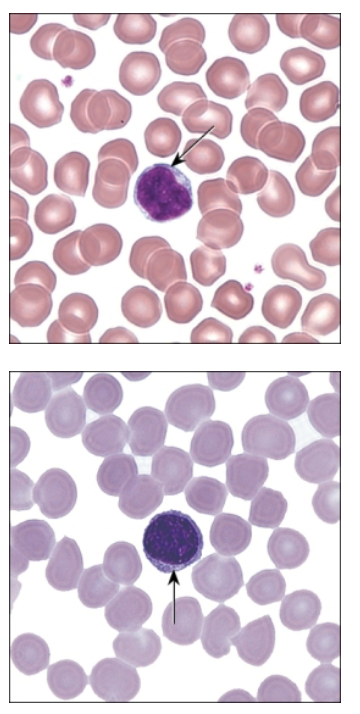
<p>Agranulocytes—lymphocytes</p><ul><li><p>20–25% of total blood leukocytes</p></li><li><p>Slightly larger than RBCs</p></li><li><p>Round nucleus that fills most of cell</p><ul><li><p>Tiny ring/crescent of cytoplasm visible</p></li></ul></li><li><p>Following development enter lymph and establish clones</p></li><li><p>Respond to antigens</p></li></ul><p></p>
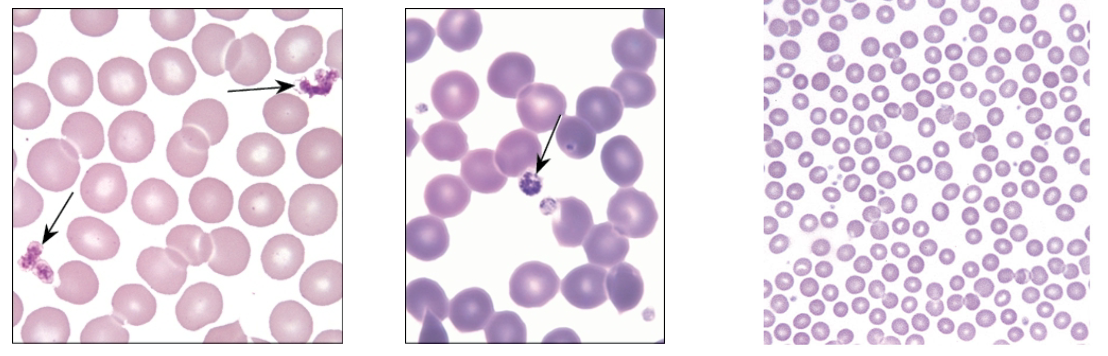
<ul><li><p>Not actually cells—cell fragments</p></li><li><p>Derived from <strong>megakaryocytes</strong> resident in bone marrow</p></li><li><p>Involved in clotting processes</p></li></ul><p></p>

1/44
Looks like no tags are added yet.
Name | Mastery | Learn | Test | Matching | Spaced | Call with Kai |
|---|
No analytics yet
Send a link to your students to track their progress
What is the cardiovascular system? What are the three basic circuits?
Consists of blood pumped by the heart through the blood vessels to the body
Three basic circuits (closed loops)
Pulmonary circuit
Dumps waste CO2 from blood into lungs for expulsion, enriches red blood cells with O2
Systemic circuit
pumps O2-enriched blood to body, then brings it back to the heart for rerouting to pulmonary circuit
Coronary circuit brings blood to heart tissue
How is the heart developed during weeks 3-4?
Myocardium – mesoderm
week 3-4
embryo too large for diffusion of nutrients
Heart has to start working before it completes development
Two endocardial tubes fuse by day 21
beating ~ day 22
Differentiates in 5 distinct regions
Bending/folding
Sinus venosus
Superior vena cava
Coronary sinus
Portion of right atrium
Truncus arteriosus
Ascending aorta
Pulmonary trunk

How is the heart developed during weeks 4-8?
Partitioning – divided into 4 chambers and great vessels form
Atrium
Interatrial septum (septum primum and septum secundum)
S. primum = one-way valve
opening = foramen ovale
Connect to endocardial cushion
Ventricle
Wall grows superiorly
AV valves, papillary muscles and chordae tendinae form from wall as well

What is the internal heart anatomy?

What is the serous membrane of the heart? What tissues are part of the heart wall?
Serous membrane = Pericardium
double lining of pericardial cavity
Visceral pericardium = epicardium
Parietal pericardium
Pericardial fluid
Heart wall
Epicardium
Visceral pericardium = SSE + loose CT + adipocytes
Myocardium - thickest
Cardiac muscle
Endocardium
SSE + loose CT


What is the layers of the heart wall?
The layers of heart wall
Endocardium
Comparable to tunica interna
Endothelium plus a loose connective tissue
Folds inward to form valve flaps
Subendocardial layer
ventricles contain Purkinje fibers for contraction
Myocardium—middle and thickest layer, cardiac muscle cells, similar to tunica media
Epicardium—on outer surface of heart
Visceral pericardium
Simple squamous mesothelium with underlying fibrous connective tissue
Layer in which coronary vessels travel

What does the myocardium and epicardium look like under microscope?

Histology of cardiac muscle images


What is the histology of cardiac muscle?
Similar to skeletal muscle fiber structure with some notable differences:
Cells short and branched
1-2 central nuclei
Intercellular connections = intercalated discs
T-tubule overlies z-disc
Increased mitochondria
Less sarcoplasmic reticulum
No terminal cisternae
What are the structural and functional differences between cardiac muscle cells and skeletal muscle fibers?

What is the cardiac skeleton?
Made of up dense connective tissue
Separates atria from ventricles
Also found at bases of pulmonary trunk and aorta
Provides attachment site for cardiac muscle
Prevents transmission of impulses from atria to ventricles
EXCEPT via the AV node

How does the heart contract?
Conducting system
Modified myocardiocytes
More slender and pale staining
Can generate and propagate AP
Regulated by sinoatrial (SA) node
At junction of superior vena cava and right atrium
Spreads signal over atria, causing contraction
Reaches atrioventricular (AV) node
Located in myocardium near tricuspid valve
Sends signal via conducting fibers of AV bundle (of His) to heart’s apex
Signal spreads upward along specialized cardiac muscle fibers (Purkinje fibers) causing contraction
Premature ventricular contraction caused by Purkinje fiber action potential

What is blood?
Specialized connective tissue with cells/formed elements (noncellular) dispersed in extracellular fluid (plasma)
Functions as a transport medium for gases, nutrients, and wastes
Involved in transporting defenses to needed sites
Distributes heat and hormones through the body
What are the formed elements of blood?
Hematocrit (packed cell volume)
Liquid = plasma
Formed elements portion is 45%
Erythrocytes (red blood cells, or RBCs)
4.2–5.4 million/4.7–6.1 million per μl of blood (females/males, respectively)
Leukocytes (white blood cells or WBCs)
4,800–10,800 per μl of blood
Platelets
Between 150,000–350,000 per μl of blood
Plasma portion is 55%
Clotted blood
Liquid = serum = plasma w/out clotting elements

What are erythrocytes?
Biconcave disc-shaped cells
7–8 μm wide, 2.5 μm thick
Develop from cells in bone marrow
Lose organelles along the way
Mainly contain oxygen-carrying hemoglobin
Active enzymes
E.g. carbonic anhydrase, glycolytic pathway
What are leukocytes?
Larger than RBCs, nucleated
Divided into two major groups
granulocytes
prominent cytoplasmic granules, possible multilobed nuclei
Neutrophils
Eosinophils
Basophils
agranulocytes
unlobed nuclei, small and less prominent granules in cytoplasm
Lymphocytes
Monocytes

What are neutrophils?
Granulocytes—neutrophils
Most abundant leukocytes (60–70% of total)
Slightly larger than RBCs
Multilobed nucleus
Small unstained or slightly lavender granules upon staining with Wright’s or Giemsa stains
Functionally short-lived phagocytic cells
What are eosinophils?
Granulocytes—eosinophils
Constitute fewer than 5% of total leukocytes
Larger than neutrophils
Bilobed nucleus
Cytoplasmic granules more pronounced and often stain reddish
Active in combating parasite infections, phagocytosing antigen- antibody complexes, and tempering allergic reactions
What are basophils?
Granulocytes—basophils
Rare in blood (fewer than 1% of leukocytes)
Slightly larger than RBCs
Prominent dark-staining cytoplasmic granules
Often obscure the S-shaped nucleus
Involved in inflammatory responses and hypersensitivity reactions
Similar to mast cells

What are monocytes?
Agranulocytes—monocytes
3–8% of all blood leukocytes
Roughly two times the size of RBCs
Bluish-gray cytoplasm in most stains with an indented/irregular nucleus shape
Blood form of tissue macrophages
Can be phagocytic and antigen-presenting cells for induction of immune responses

What are lymphocytes?
Agranulocytes—lymphocytes
20–25% of total blood leukocytes
Slightly larger than RBCs
Round nucleus that fills most of cell
Tiny ring/crescent of cytoplasm visible
Following development enter lymph and establish clones
Respond to antigens
What are the three functionally distinct subsets of lymphocytes?
Three functionally distinct subsets
Morphologically indistinguishable!
B cells—differentiate into antibody-secreting plasma cells in response to antigens,
Bone marrow derived
T cells—helper, suppressor, memory, and cytotoxic;
Migrate to and mature in Thymus
Cell mediated immunity
Natural Killer cells—lack membrane markers of B/T cells; “null cells”
kill cells missing “self” marker MHC class 1; tumor suppression
Lymphomas = cancer of lymphocytes
What are platelets?
Not actually cells—cell fragments
Derived from megakaryocytes resident in bone marrow
Involved in clotting processes

What is the composition of bone marrow?
In marrow cavity of long bones, between spongy bone trabeculae
Highly vascular; numerous blood sinusoids
Framework of reticular fibers; cells of various types
Shifts with age from red to yellow bone marrow
Responsible for blood cell formation (hemopoiesis)

What do pluripotent stem cells in the bone marrow produce?
Hemopoiesis is complex
Basic scheme
Pluripotent stem cells in bone marrow produce two basic types of stem cells
Myeloid stem cells
eventually produce erythrocytes, megakaryocytes, granulocytes, and monocytes
Lymphoid stem cells
eventually produce the various subsets of lymphocytes
Each stem cell type gives rise to progenitor cells that gradually become more and more differentiated into each cell type under different control cues


What is Granulopoiesis?
Granulopoiesis—production of granulocytes
Myeloblasts give rise to promyelocytes with nonspecific granules
Myelocytes have developed granules specific to a particular granulocyte subset
Metamyelocytes are smaller with an indented nucleus
Band (stab) cells are the last stage before they enter blood
Fully mature granulocytes


What is Erythropoiesis?
Erythropoiesis—RBC development
Development goes through several stages
Each stage leads to progressive decrease in size, loss of organelles, and increase in hemoglobin
Nucleus is lost at reticulocyte stage
Process is estimated to produce 250 billion RBCs each day!


What is Thrombopoiesis?
Thrombopoiesis—platelet production
Megakaryocytes arise in the bone marrow
Develop from megakaryoblasts
Large polyploid cells
Break off fragments of themselves to form platelets that leave bone marrow and enter periphery
Estimated production of 150 billion platelets per day!


What is the basic blood vessel structure?
Share a common structure
Three layers
Innermost = tunica (intima) interna
Simple squamous endothelium
contain Weibel-Palade bodies
Store/release von Willebrand factor
Important in platelet adhesion
thin layer of connective tissue
Internal elastic lamina
Middle = tunica media
Varying amounts of smooth muscle
External elastic lamina
Sympathetic innervation
Outer = tunica (adventitia) externa
Dense irregular CT
Largest vessels may be penetrated by smaller vessels (vasa vasorum) to deliver oxygen to large vessel cells

What are the types of blood vessels?
Arteries, veins, and nerves typically travel together to form a neurovascular bundle
Three main types
1. Arteries
Elastic arteries
Muscular arteries
Arterioles
2. Veins
Large veins
Medium veins
Venules
3. Capillaries
Continuous
Fenestrated
Sinusoidal

What is the function of arteries?
Carry blood away from the heart at high pressure
Thicker walls than veins
Aorta and pulmonary trunk exit heart
Branch into smaller and smaller arteries
Eventually lead to capillaries of systemic and pulmonary circuits, respectively
Elastic tissue decreases/smooth muscle increases as arteries get smaller


What is the function of elastic arteries?
Largest; include pulmonary trunk/aorta
Tunica media with fenestrated membranes (lamellae) elastic tissue
Alternates with smooth muscle
Internal and external elastic membranes also present
Allows walls to expand, then recoil to help push blood along
Very thin tunica externa, often with vasa vasorum


What are muscular arteries?
Larger than 0.5 mm in diameter
Wavy internal membrane
Up to 40 layers of smooth muscle in tunica media
Tunica externa has collagen/elastic fibers as well as smooth muscle fibers
Distinct fibers in the tunica intima


What are arterioles? What connects arterioles to venules?
Smallest arteries; 30–200 μm in diameter
Tunica media = one to a few layers of smooth muscle
Tunica externa roughly same size as tunica media
Blood flow into capillaries regulated by precapillary sphincters
Arteriovenous anastomosis directly connects arterioles to venules, allows bypass of capillary bed (can be used to regulate body temp

Aorta vs Muscular Artery vs Arteriole
Distinct fibers in the tunica intima


What are capillaries?
Smallest blood vessels; 4–10 μm in diameter
Consist only of endothelium and basal lamina
Contractile pericytes may be present to regulate blood flow


What are the three types of capillaries?
Capillaries are of three types:
continuous: muscle, nervous, connective tissues
modified continuous: brain tissue
fenestrated
sinusoidal
Continuous capillaries
The intercellular junctions between their endothelial cells are a type of fasciae occludentes, which prevent passage of many molecules. Substances such as amino acids, glucose, nucleosides, and purines move across the capillary wall via carrier-mediated transport. There is evidence that barrier regulation resides within the endothelial cells but is influenced by products formed by the astrocytes associated with the capillaries.
Fenestrated capillaries have pores (fenestrae) in their walls that are 60 to 80 nm in diameter and covered by a pore diaphragm. These capillaries are found in the pancreas, intestines, and endocrine glands.
The pores in fenestrated capillaries are bridged by a diaphragm. Anexception is the renal glomerulus, composed of fenestrated capillariesthat lack diaphragms.
Because of their location, sinusoidal capillaries have an enlarged diameter. They also contain many large fenestrae that lack diaphragms; the endothelial wall may be discontinuous, as is the basal lamina, permitting enhanced exchange between the blood and the tissues.
Sinusoids are lined by endothelium. Although the endothelial cells lack pinocytotic vesicles, macrophages may be located either in or along the outside of the endothelial wall.

Three types recognized
Continuous: complete endothelial lining, most common
Fenestrated: 60–80 nm diameter membrane-covered pores present
Sinusoidal: larger, discontinuous endothelium promoting exchange


Longitudinal & transverse sections of capillaries
In zona fasciculata in the kidney

What is the function of veins?
Carry blood toward heart under low pressure
Thinner walls than arteries
Begin at capillaries, end at heart as either inferior/superior vena cava or one of the pulmonary veins
May have endothelial folds that form valves to resist downward pull of gravity
Walls are generally thin and indistinct; thickest layer is tunica externa

What is the function of venules?
Smallest veins
Structurally similar to capillaries, but larger in diameter
Pericytes present as they leave capillary beds
Replaced with smooth muscle as venules get bigger


What is the function of medium veins?
Medium veins—less than 1 cm in diameter
Tunica interna = endothelium and connective tissue, no internal elastic membrane
Tunica media = smooth muscle
Tunica externa = collagen/elastic fibers
Valves present in systemic veins working against gravity

What is the function of large veins?
Large veins
Thicker tunica interna
More connective tissue
Tunica media
thin
Tunica externa thickest layer
Composed of elastic/collagen fibers; vasa vasorum

Tunica intima, media, and adventitia within the artery

Tunica intima, media, and adventitia within the vein
